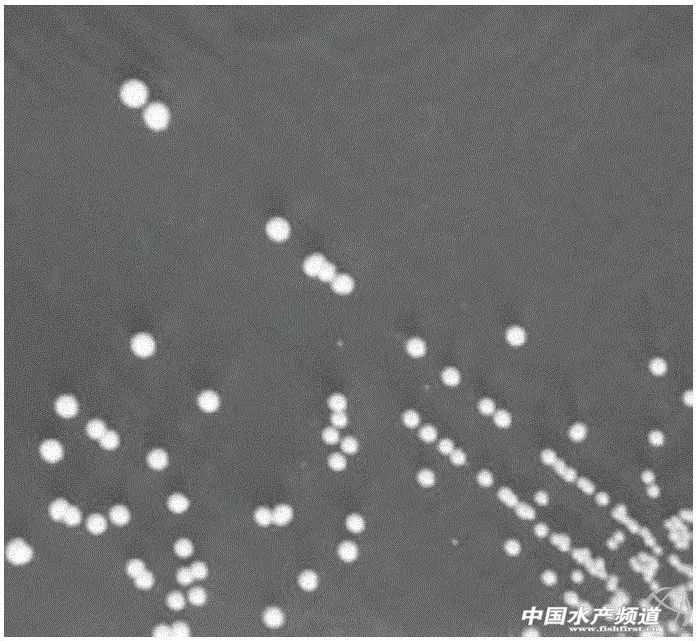
水产养殖中微生物制剂都有哪些,水产微生态制剂使用原则和方法

中国水产频道报道,近年来,人们开始尝试在养殖水体中施用有益微生物制剂来改善养殖生态环境,提高养殖动物的免疫力,抑制病原微生物,从而减少疾病的发生。微生物制剂是由一些对人类和养殖对象无致病危害并能改良水质状况,能抑制水产病害的有益微生物制成。主要有硝化细菌、光合细菌、枯草杆菌、放线菌、乳酸菌、酵母菌、链球菌和EM微生物菌群等。它们具有改良水质、增加溶氧、降低氨氮、抑制致病菌生长、改善动物体内水环境生态平衡、提高动物抗病与免疫力,促进养殖对象生长等功能。
如今我国微生态制剂虽在水产养殖中取得了不错的效果,但存在的问题仍是显而易见的,要想水产微生态制剂能有一个良好的发展前景,正确认识和使用水产微生态制剂变得十分关键。尽管有益微生物制剂在水产养殖业的应用结果表明其有许多优点,研究和开发工作日益加深,应用范围也日益扩大,但仍存在一些问题和待研究领域,这一点应引起足够的重视。

微生物制剂是将自然界有益细菌通过人工筛选培育,再经过生物工程工厂化生产出来,用于生态调控及动物营养保健的活菌制剂。现在市场上销售的这类产品名目繁多,如EM菌、光合细菌、芽孢杆菌、硝化细菌、乳酸菌、酵母菌等,都属微生物制剂的同类产品。就有益菌种来讲,美国发布了40种安全有效的有益菌种,我国农业部允许使用的有益菌种有干酪乳杆菌、嗜乳酸杆菌、乳链球菌、枯草芽孢杆菌、纳豆芽孢杆菌、啤酒酵母菌、沼泽红假单胞菌等12种。依活菌种的组成,有单一菌制剂和复合菌制剂。市售的多为复合菌制剂,只是其中的菌种种类和数量有别而异。
应用于水产养殖上的微生态制剂按用途可分为两大类:内服、外用。
一类是内服。以提高鱼虾免疫力的饲料微生态添加剂,目前应用较多的菌类有乳酸菌、芽孢杆菌、酵母菌等;
另一类是外用。以改良水质的微生态调控剂,主要菌类有光合细菌、芽孢杆菌、硝化细菌等。各类菌有其自身特性,使用时要针对不同目的采用不同方法,才能最大限度地发挥其功效。

微生物制剂可有效降低养殖水质中亚硝酸盐、氨氮、硫化氢等浓度,抑制水体中有害微生物繁殖和生长,净化水质。
微生物制剂可使养殖动物提高机体免疫力。防止水产养殖动物体内有害物质产生。同时,转化养殖动物肠道、血液及粪便中有害物质浓度,降低有害物质在机体内的累积,有利于机体的健康。
微生物制剂具有投资小、效益高、使用方便等优点。既能全池泼洒,也能做为饲料添加剂。无毒、无害、无药物残留,长期使用可以减少养殖过程中抗生素的使用量,减少病害发生,排放的污水对环境污染也较小。

自然水体自身存在一定的细菌生态平衡系统,施用微生态制剂是人为改变条件,定向培育优势菌群并发挥其作用,形成新的动态平衡。在微生态制剂的使用过程中,首先要根据水体的理化因子正确选用菌种;其次,施放微生态制剂要达到一定的浓度、确保水体中活菌数达到一定数量,并营造适合培育菌种的生长条件,使之尽早形成并维持优势菌群,以取得良好的使用效果。


光合细菌(Photosynthetic bacteria,简称PSB)是广泛分布于水田、河川、海洋和土壤中的一种微生物类群。光合细菌为革兰氏阴性细菌,光合细菌作为养殖水质净化剂,目前国内外均已进入生产性应用阶段。可以在有光无氧的条件下生长、繁殖,也可在无光有氧的条件下生长。有光时菌体能利用光能,以硫化氢(H2S)和有机物作为氢供体,以二氧化碳(C02)或有机物作为碳源而生长发育。当环境是有氧无光时,菌体则可以通过有氧呼吸,使有机物氧化,从中获取能量。
在水产养殖中应用较多的有红螺菌科的荚膜红、沼泽红、球形菌、深红红螺菌等种类,大多数种类为厌氧性或兼性厌氧性。光合细菌细胞内含有类似于植物叶绿素的细菌叶绿素,在无氧和无光照条件下,利用水体中有机物进行不产氧的光合作用。
光合细菌细胞内含有类似于植物叶绿素的细菌叶绿素,在无氧和无光照条件下,利用水体中鱼虾残饵及排泄物等有机物进行不产氧的光合作用,合成大量菌体。所以其增氧机制是通过同化水中有机物,减少有机耗氧来实现的。光合细菌还能以硝酸盐或亚硝酸盐作为生理代谢上的氧化剂,吸收利用水中的硝酸盐及亚硝酸盐。不少光合细菌还利用硫化物。以上机制形成了光合细菌很强的净化水质的功能。
在水温28℃——36℃ ,pH偏碱(7.5——8.5)时,光合细菌生长较好。对有机物浓度较高、底质较差、有一定透明度的浅水池使用效果明显。这是因为有机物高的底质易形成无氧条件,有一定透明度满足光合细菌大量生长、繁殖的要求。养殖户在使用光合细菌改善水质时,可选在晴天上午进行,光合细菌用沸石粉吸附后泼洒能提高使用效果。
由于水中光合细菌的浓度会因换水及生物吞食而降低,不能稳定地发挥净化水质的功能,已有人尝试将光合细菌固定化并应用于试验和生产中,使净化水质的效果得到进一步的改善。由于光合细菌制品多为活菌液,为保证使用效果,应注意尽量使用新鲜菌液以保证活菌数。成品菌液应先逐渐降温而后存放在温度较低(15℃ 以下)并有一定光照的地方(每天2 小时以上),然后逐渐减少光照,再置于阴凉避光处。菌液开始发黑并有恶臭味可能是活菌死亡腐败所致,使用效果不佳。

芽孢杆菌,革兰氏染色阳性,是普遍存在的一类好气性细菌,枯草芽胞杆菌的分布非常广泛,土壤、湖泊、海洋、动植物体表及其栖息地皆能发现。该类菌无毒性,能分泌出活性强的蛋白酶等多种酶类,在其生命过程中又能以孢子体形式存在,易于生产和保存,作为饲料微生态添加剂和水体微生态调控剂都有广阔前景。枯草芽胞杆菌在生长繁殖过程中能够产生B1 、B2、 B6等B族维生素和维生素C、维生素K2,为水产动物提供维生素营养,日常食用的纳豆芽孢杆菌就能产生大量的维生素K2。
枯草芽孢杆菌能大量消耗水体中的有机质,将其分解为小分子有机酸、氨基酸及氨,枯草芽孢杆菌改善水质,为单胞藻提供营养,还可使肠道PH及氨浓度降低,净化水质。在水体中使用枯草芽孢杆菌制剂后,对养殖水体的溶氧和PH无明显影响,但对氨氮、亚硝酸盐和硫化物均有大幅度降低。
枯草芽孢杆菌作为水产微生物饲料添加剂的菌株,在生产中的应用比光合细菌、硝化细菌、乳酸菌等菌株晚。随着近几年在水产养殖中的应用实践,枯草芽孢杆菌类微生物饲料添加剂充分显示出以下的优势:枯草芽孢杆菌稳定性好、抗性强,具有耐高温、耐酸碱、耐挤压等特点,枯草芽孢杆菌在工业生产制粒过程中以及通过养殖动物酸性胃环境时均能保持高度稳定性。芽孢一旦形成,便能耐受各种不利条件,如干热、湿热、紫外线、射线、强酸、强碱、有机溶剂、真空干燥、氧化作用等。
枯草芽胞杆菌的生物学性质与作用机理,枯草芽胞杆菌是一种短杆状、无荚膜能运动的革兰氏阳性细菌,能产生中生芽胞,最适生长条件为:温度37℃,pH值7.0左右,一般为严格好氧。
芽孢杆菌作为水体微生态调控剂的作用机理,是通过经筛选出有类似于硝化细菌功能的菌株,可以降低水体中硝酸盐、亚硝酸盐的含量,从而起到改善水质的作用。芽孢杆菌还可以通过消灭病原体或是至少减少了病原体的影响来改善水质。实验发现添加芽孢杆菌控制弧菌等致病菌比加抗生素更好,许多不同的抗生素是由一系列的芽孢杆菌所产生,许多细菌在同一时间不可能对所有抗生素都有抗性基因,特别是如果它们以前未曾与芽孢杆菌有过接触时。芽孢杆菌能分泌许多降解粘液和生物膜的酶,使得芽孢杆菌及其产生的抗生素能渗透进革兰氏阴性菌的粘液层;另外,芽孢杆菌与其它细菌竞争营养并且抑制其快速生长。基于以上功能,加上芽孢杆菌在生产过程中易保存等特点,芽孢杆菌制剂正成为目前研究和生产应用的热点。

芽孢杆菌在保存期间以芽孢的形式存在,养殖户在使用前,可用一定配制好的培养基活化、增殖,然后泼洒,可提高使用效果。由于大多数芽孢杆菌属好气性菌,需要有充足的溶氧其使用效果才好,在施用芽孢杆菌制剂时要注意保持水体中的溶氧量,以更好地发挥其作用。

硝化细菌属化能自养菌,专性好氧,大多是专性无机型。硝化细菌可分为2个亚群:亚硝化细菌和硝化细菌。亚硝化细菌将水体中的氨氧化为亚硝酸氮,硝化细菌将亚硝酸氮氧化为对水生动物无害的硝酸氮。硝化细菌是一类自养型生物,尤其是亚硝化细菌,无法利用现成的有机物,水体中无机物太多反而会抑制其生长。与异养性细菌相比,硝化细菌的繁殖周期特别长,因此在水中很难形成优势菌群。
硝化细菌的主要作用是降解水体中的氨氮,如果水体中无机盐类如游离态氨(NH4+)等营养元素大量存在,能更好地促进硝化细菌的生长,起到明显的降氨氮效果。

使用硝化细菌有2种方法,一种是应用预先培养附着硝化细菌的生化培养球;另一种是向池中直接泼洒硝化细菌制剂。硝化细菌发挥作用的适宜条件为:pH 值7——9,低于6不利硝化细菌生长;水温在30℃ 时活性最高;水中溶解氧对硝化细菌作用影响很大,和光合细菌一样,也需要有充足的溶氧其使用效果才好,溶解氧含量高则硝化作用能更好进行。此外,光对硝化细菌的生长繁殖有抑制现象。建议在使用硝化细菌制剂时,要注意水中溶解氧含量及光照强度。

EM菌 (有效微生物菌群)是采用适当的比例和独特的发酵工艺将筛选出来的有益微生物混合培养,形成复合的微生物群落,并形成有益物质及其分泌物质,通过共生增殖关系组成了复杂而又相对稳定的微生态系统。
"EM"为有效微生物群的英文缩写,由光合细菌、乳酸菌、酵母菌等5科10属80余种有益菌种复合培养而成。EM具有结构复杂、性能稳定、功能广泛、使用方便、价格便宜,促进动、植物生长,增强抗病能力,去除粪便恶臭,改善生态环境,提高成活率等优点。
EM菌中的有益微生物经固氮、光合等一系列分解、合成作用,可使水中的有机物质形成各种营养元素,供自身及饵料生物的生长繁殖,同时增加水中的溶解氧,降低氨、硫化氢等有毒物质的含量,减少换水次数。

另外,EM菌与动物肠道内有益菌的大量增殖,能够抑制大肠杆菌的活动,并促进机体对饵料的消化吸收,从而降低蛋白质向氨和胺的转化,使排泄物中的氨氮含量减少,达到净化水质、促进生长的作用。由于池塘泼洒EM菌后,水质相对较清,故这些塘不宜或少养肥水鱼,如鲢、鳙等鱼。
复合微生物制剂是采用存在于自然环境中的多种微生物菌株经诱变选育,扩培后得到混合菌剂。应用复合微生物制剂对养殖水体进行处理,它能有效降解有机淤泥,抑制有害微生物和有害藻类的繁殖,平衡养殖水体的微生态环境,促进养殖生物健康生长,利用这一菌剂对养殖水体的微生态环境进行调控,是目前水产养殖中水处理的一种较为理想的办法。
在养殖池添加比如以芽孢杆菌属菌类为主导菌的微生物复合制剂时,利用其需氧微生物与厌氧微生物共栖,兼有需氧与厌氧代谢机制的特性,迅速而彻底地降解进入养殖池的有机物,减少有机物在池底的沉积,避免有毒因子的产生。
现在,许多学者和生产厂家试图利用不同菌株的不同特性,将多种微生物菌株培育后复合为复合微生态制剂,以期发挥它们的综合效果。但由于不同微生物菌株的生长、繁殖条件不同,同一水质条件能否同时满足所有复合菌株发挥作用,值得进一步深入研究。

从抗生素的替代实践证明,一种新产品的安全性评价需要一个较长的过程。对有益微生物制剂的毒副作用等问题目前还未见有报道,人们对此还缺乏了解,但并不表明不存在这方面的问题,有益微生物制剂的天然性并不能从逻辑上就能保证其是安全的。事实上,大多数有益微生物制剂并非单纯制品,常含有培养基残留物、无机盐、防腐剂和稀释剂等,大多数属未知成分,因此,发酵菌种、杂菌污染、培养基原料、酶的化学性质、杂质的种类和含量等因素都有可能影响到有益微生物制剂的安全性;此外,由于目前还没有国家统一的质量标准,很多菌种在投入生产前及生产过程中缺乏生物学、遗传学特征的检验,可能存在一定的安全隐患。
具体而言,这一问题包括这些方面:如选用菌种没有进行针对性的选择和严格驯化,可能对水产动物和人的健康存在潜在威胁;菌种的变异使得产品质量得不到保证;缺少对代谢产物的系统研究,一株现在无毒无副作用的菌种无法保证其长期安全;在开发生产过程中常有偏重于产生抑菌作用的倾向,病原菌生长时间与其接触有可能产生抗性,等等。
虽然目前有许多商品性的有益微生物制剂应用于水产养殖业,但大多数是为陆生动物设计的,有的菌株并不适合水产养殖动物的消化和养殖水体的环境,因水产养殖动物为低等动物或冷血动物,其消化道内的微生态系统与陆生动物有很大不同,养殖水体环境也与陆地环境有很大不同,在选择菌种时应引起充分注意,要在研究基础上加以选择和确认。
有益微生物制剂对养殖水体的生物修复存在一定局限性,养殖水体的水型较为复杂,有海水、内陆盐水、淡水之分,也有按盐型的不同划分的盐酸盐型、碳酸盐型、硫酸盐型、硝酸盐型等水型,而每一种微生物都有其特定的生存适应环境要求,有益微生物制剂中的特定有益菌只能降解特定类型的化学物质,状态稍有变化的化合物就不可能被同一微生物所降解或破坏,有益微生物制剂并不能适用于所有养殖水体环境或不能降解所有养殖环境中的有毒有害物质。因此,要在已有的研究基础上,研究测水施用技术。对于不同水型确定不同微生物种的配伍、用法与用量等技术内容,确保使用的有效性。
另外,许多养殖户对有益微生物制剂一知半解,或受广告夸大宣传的影响,简单地认为使用有益微生物制剂是只要向池中泼洒既可,不管是什么菌种的制剂、有何使用要求等,使用上存在着盲目性问题。事实上,因有益微生物制剂是由活菌组成的,其作用的发挥与施用活菌的数量、时间、气候、水质条件等均有直接影响;且有益微生物制剂只有在水体中增殖到优势种群后才能发挥作用,这需要几天的时间才能反应出来,应在使用后加以观察和检测有关指标。

许多微生态制剂源于环保制剂,当应用于水产养殖时,应注意菌株的特异性,考虑对水生生物的安全性,如假单胞菌中的荧光假单胞菌和铜绿假单胞菌对鱼类就是病原菌。目前,除光合细菌外,其他的微生态制剂尚无国家统一的产品标准。国内生产厂家众多,产品难免鱼龙混杂,所选的菌种应进行针对性的选择和严格的驯化,防止对渔业生产和人的健康造成损害。因此,应选择那些有研发实力,技术成熟的生产厂家的产品,确保产品的安全性。
目前市场上常见的应用于水产上的微生态制剂产品不是很多,根据其在水产殖中的应用大致可分为两类:
实际应用时,应该根据具体的要求,合理选择微生态制剂,发挥它的最大效力。近年许多学者和生产厂家试图利用不同菌株的不同特性,将多种菌株培育后复合,以期发挥他们的综合效果。但由于不同菌株的生长,繁殖条件不同,同一环境条件难以同时满足所有复合菌株发挥作用的要求,其作用值得进一步探讨。
使用微生态制剂时,一定要注意菌体的数量和活力,一般要求每毫升含3亿个以上的活菌体,且活力要强。试验表明,随着微生态制剂保存期的延长,活菌数量逐渐减少,其作用效果明显降低。所以除应注意妥善储存外,还应尽早使用,制剂的颜色和气味发生明显变化,则可能意味着菌体已开始死亡腐败,尽量不要再使用。
除了注意保持原有产品中菌体活性外,还可采取适当的活化措施提高菌体的活性,增强使用效果。
芽孢杆菌在保存期间以芽孢的形式存在,可通过配制好的培养基进行活化,增殖,然后泼洒;
使用EM菌时最好按1∶1的比例加入糖蜜红糖水,搅拌均匀后放置半小时左右,促进菌体活化。
各种环境因子都可能对微生态制剂产生一定的影响,我们应把不良影响降到最小,选择适宜的水环境,一般控制pH 6-8,水温15-35℃,水体溶解氧2毫克/升以上。
pH值低于7或者高于8.5的水体,以及溶解氧含量低的水体,不利于硝化细菌的生长;
光对硝化细菌的生长,繁殖也有一定的抑制作用,它和光合细菌相反以不要或微弱光照为宜。
因此,在使用微生态制剂前,应测定有个水环境因子的指标,依此选择相适应的微生态制剂,并通过改进措施,达到最为理想的效果。
由于微生物制剂起效具有滞后性,要发挥微生态制剂的治本防治作用,就必须提前使用。尤其是在幼苗开食,食性转换,季节变化,鱼病高发等关键时期,提前使用微生态制剂,才能够收到良好的防病效果。
微生态制剂进入水产动物体内或者水体环境中,有益菌的数量具有先增后降的生长周期,其长短与菌群种类,密度,水体肥瘦,有害菌的数量等密切相关,一般为20-30天。所以在应用中应参考水体的透明度以及水质化学指标,及时调整。
首先要协调好与其它技术措施的关系,禁止与抗生素,杀菌化学药以及具有抗菌作用的中草药,杀虫剂等同时使用,在施微生态制剂后的生长周期内,尽量不使用化学药物,尽量加水不换水。
此外应按照“交叉交替”原则进行使用,即根据不同的养殖期,不同的水质要求,交叉使用不同类型的微生态制剂,通过外用与内服相结合,泼洒与拌饵的交替使用,不仅使有益菌在养殖环境中形成优势菌群,而且在水产养殖动物体内也成为优势菌群,保障水产养殖动物始终处在健康的生长环境中。
很多存在的问题是由于使用不规范引起的,要想微生态制剂这一市场协调发展,应该对从事水产养殖业和微生态制剂销售人员进行专业的技术培训,提高其专业素质,使他们对微生态制剂有一个全面,客观的了解;要求厂家生产规范,且在做广告推介时,不允许任意夸大其微生态制剂产品的作用,以免误导养殖户;不同的微生态制剂,有着不同的生物学特征,因此对微生态制剂的储运管理必须强调个体化原则,根据其不同的生物学特性,采取相应的管理方法。